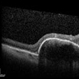

-
 By From the Collections of Thomas M. Aaberg, MD and Thomas M. Aaberg Jr., MD
By From the Collections of Thomas M. Aaberg, MD and Thomas M. Aaberg Jr., MD
- Uploaded on Feb 20, 2013.
- Last modified by Chayal Patel on Apr 16, 2013.
- Rating
- Appears in
- Miscellaneous
- Condition/keywords
- disc hypoplasia, tilted disc
- Description
- Disc hypoplasia; tilted disc and field defect.


 Initializing download.
Initializing download.